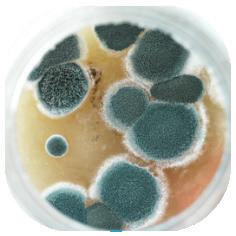

www.bettaelectrical.co.nz Not all products available in all stores, but can be ordered or purchased online Valid from Monday 3rd July to Tuesday 25th July 2023 www.bettaelectrical.co.nz Whip up a winter warmer with Haier & Betta Electrical Purchase any Haier oven or cooktop and receive a bonus Di Antonio Forano 4.6L cast iron casserole dish worth $249! * BONUS GIFT HDW13V1W1 13 Place White Dishwasher $ 629 $ 849 $ 578 $ 669 $ 329 $ 369 Save $170! Save $120! Save $200! All of our stores have expert teams who help you to make a Betta choice and choose the right product to suit your needs. Betta Electrical only sell brands we love and trust! Spice up your life with these red hot deals on cooking appliances and more! EDCC604T Eurotech 60cm Black 4 Zone Ceramic Cooktop with Touch Controls *T&C at www.bettaelectrical.co.nz HWO60S7MX4 Haier 60cm S/Steel 7 Function Built-in Oven HCE604TB3 Haier 60cm 4 Zone Ceramic Cooktop EDBIO8FDTSS.2 Eurotech 60cm S/Steel 8 Function Built-in Oven EDCAMINO60 Eurotech 60cm S/Steel Wall Canopy Rangehood SRCN108WST 5 Cup Rice Cooker $ 179 $ 1399 Save $500 EDEUROC60SS 60cm S/Steel 7 Function Catalytic Freestanding Cooker M IX MATCH and DEALS WORTH SHARING! Master amazing family snacks & meals! More ideas page 5! July 2023





$1029 $999
$2299 $699 $1139
$1299
















LOOKING FOR FRIENDLY, KNOWLEDGEABLE, AND EFFICIENT CUSTOMER SERVICE? Come and talk to us! Whip up a winter warmer with Haier & Betta Electrical Purchase any Haier oven or cooktop between 4-28 July and receive a bonus Di Antonio Forano 4.6L cast iron casserole dish worth $249! * $ 578 $ 849 $ 699 $ 849 $ 1029 $ 1299 $ 349 $ 399 $ 669 $ 499 $ 449 $ 399 $ 529 $ 249 Save $199! Save $100 Save $170! Save $70 Save $500! Save $220! HCE604TB3 Haier 60cm 4 Zone Ceramic Cooktop • 52H x 590W x 520D • Touch controls and simple, intuitive usability • Spill detection alert HWO60S7MX4 Haier 60cm S/Steel 7 Function Built-in Oven • 595H x 595W x 568D • Seven oven functions including Fan Forced, Pizza Plus and Pastry Plus • Cool-to-touch door for safety HWO60S14EPB4 Haier 70L Black 10 Function Pyrolytic Oven • 595H x 595W x 569D • Clever Rotisserie accessory for a superb roast • Pyrolytic Self-cleaning function HCG604WFCG3 Haier 60cm Black Glass 4 Burner Gas Cooktop • 98H x 580W x 500D • Single surface cast iron trivets HCI604TB3 Haier 60cm 4 Zone Induction Cooktop • 60H x 590W x 520D mm • Four zones with precise heat control • Cool-to-touch for safety HWO60S7EB4 Haier 70L Black 7 Function Oven with Air Fry Tray • 595H x 595W x 569 • Seven oven functions including Air Fry, Pastry Plus and Pizza Plus • Self-cleaning catalytic side panels Made in Europe RHCERAM60TPROMO Robinhood 60cm Ceramic Cooktop Touch Control • 41H x 590W x 520D • 4 cooking zones • 6000W • Front touch control EDBIO8FDTSS.2 Eurotech 60cm S/Steel 8 Function Built-in Oven • 595H x 595W x 567D • 76-litre capacity • Catalytic liners • Digital control timer EDCC604K Eurotech 60cm Black 4 Zone Ceramic Cooktop • 68H x 580W x 510D • Stainless steel knobs • Bevelled edge • Side control panel EDIC604 Eurotech 60cm Black Glass 4 Zone Induction Cooktop • 60H x 590W x 520D • 9 heat settings • Touch control • Front control panel EDRIGEL60 Eurotech 60cm S/Steel Canopy Rangehood • 450-750H x 600W x 450D • 3 Speed Push Buttons • 2x Aluminium washable filters HEG604FKG Robinhood 60cm 4 Zone Ceramic Cooktop • 50H x 580W x 510D • 4 Cooking Zones • Easy to Clean Surface • Ergonomic Knobs Control RHBO65MX Robinhood 60cm S/Steel & Black Glass Built-In Oven • 595H x 595W x 575D • 75L capacity oven • 5 functions • Triple layered glass door RWK3CL6G 60cm S/Steel Curved Glass Canopy • 450-845H x 595W x 400D • Three power levels • Twin LED lamps • Push button control • Modern styled curved glass hood *T&C at www.bettaelectrical.co.nz Designed to pairwith aHaier black wall oven M IX MATCH M IX MATCH and and Reduce steam and odours from cooking for a healthy, dry kitchen. 3
Cooking combinations to match your lifestyle




The right combination of cooking appliances gives freedom of expression in the kitchen, whether creating catering for entertaining groups of friends, or cooking a nutritious dinner for the family on a busy weekday.










a cooking suite that matches your lifestyle and the way you cook and entertain.


4 PHONE US (09) 969 1930 CLICK AND COLLECT SHOP YOUR WAY... GO VISIT US ONLINE bettaelectrical.co.nz PM4800 Pie Magic Traditional 4 Up Pie Maker 4443BSS 3.5L Slow Cooker Whether it's gas, induction or ceramic, we've got you covered with brands you can trust! FPM4000DF DiamondForce™ Banquet Frypan $ 1249 $ 2494 $ 1799 $ 2199 $ 2399 $ 1449 $ 1249 $ 1999 $ 798 $ 2699 $ 99 $ 64 $ 109 Save $19 Save $10 CI604DTB4 Fisher & Paykel 60cm Induction Cooktop • 59H x 600W x 530D • 4 Cooking Zones can be bridged to form one SmartZone • SmartZone indicator CE604DTB1 Fisher & Paykel 60cm Touch & Slide 4 Zone Ceramic Cooktop • 58H x 600W x 530D • 1-9 heat settings • 4 cooking zones including a dual element • Touch&Slide selector • HiLight® high speed ribbon elements OB60SC5CEX3 Fisher & Paykel 60cm S/Steel 5 Function Oven • 598H x 597W x 565D • Generous 85L total capacity • Five oven functions including Pizza Bake • With AeroTech™ technology for even heating OB60SD9PLX1 Fisher & Paykel 60cm 9 Function Self Cleaning Oven • 598H x 596W x 565D • 85L total capacity • Nine oven functions including Pizza Bake & Roast
Moisture level control with ActiveVent technology • Pyrolytic self-cleaning function OB60SD11PB1 Fisher & Paykel 60cm Black 85L 11 Function Pyrolytic Oven • 598H x 596W x 565D • 85L total capacity • 11 oven functions including Pizza Bake and Roast • Moisture level control with ActiveVent™ technology • Pyrolytic self-cleaning function HC90DCXB3 Fisher & Paykel 90cm Wall Chimney Rangehood • 595-1035H x 898W x 500D • 3 Fan Speeds • Effective and Quiet • Easy Cleaning PKE611CA2A Bosch 60cm Black Glass Ceramic Cooktop Series 2 • 46H x 592W x 522D • 4 Cooking Zones • Sword Mounted Knobs • 4 Stage Residual Heat Indicator HBA534ES0A Bosch 60cm S/Steel Built-in Oven Series 4 • 595H x 594W x 548D • 71L Cavity Volume • 7 Heating Methods DWB65BC50A Bosch 60cm S/Steel Chimney Canopy 550-725H x 598W x 500D LED lighting 3-Speed Power Level Options Dishwasher safe aluminum mesh filters HXR39KI50A Bosch 60cm S/Steel Dual Fuel Freestanding Cooker Series 4 • 850H x 600W x 600D • 66L Capacity • 4 Gas Burner including Wok Burner
•
Bring
together
M IX MATCH M IX MATCH and and Eco-Clean Direct






















LOOKING FOR FRIENDLY, KNOWLEDGEABLE, AND EFFICIENT CUSTOMER SERVICE? Come and talk to us! GRM2000SS Cafe Style 2 Slice Sandwich Maker Grill & Press JMP1000WH Mixmaster Hand Mixer White RHSC650 6L Searing Slow Cooker RHSP801RED 4 Slice Sandwich Press SRCN108WST 5 Cup Rice Cooker $ 1099 $ 1199 $ 1269 $ 1399 $ 1399 $ 1629 $ 87 $ 59 $ 179 $ 1 59 $ 99 $ 169 $ 84 $ 239 $ 59 Save $200 Save $500 Save $800 Save $700 Save $430 $ 72 Save $10 Save $15 Save $10 Save $50 Save $50 AFEE133/1 60cm Solid Hotplate Freestanding Cooker 910H x 600W x 600D 7 Function Fan-assisted Oven 4 Solid EGO Elements Storage Compartment AFEC1500 60cm S/Steel Ceramic Freestanding Cooker 910H x 600W x 600D Ceramic Hob 9 Function Fan-forced Oven 4 Hi-light Elements 70L Oven Capacity EDEUROGE60BK 60cm Black Dual-Fuel Freestanding Cooker 900H x 600W x 600D 76-litre capacity 7 cooking functions Catalytic liners Gas cooktop Also available in Black and 90cm EDEUROC60SS 60cm S/Steel 7 Function Catalytic Freestanding Cooker • 900H x 600W x 600D • 76-litre capacity Catalytic liners Ceramic cooktop AGE152/2CT 60cm Cooker with Gas Hob • 910H x 600W x 600D • 70L Volume • 4 Burner Gas Hob w. 3.8Kw Wok Burners • 8 Functions includingFanforced, Grill & Fan Grill • Fan-Forced Electric Oven WLE625WC 60cm White Electric Freestanding Cooker • 1150H x 596W x 620D mm • Electric fan forced oven • Multifunction oven • Easy clean formed shelf supports • Easy reach rear controls • Digital Programmable timer • Handy warming drawer • 80L gross capacity oven GR6250 Big Fill Toastie for 2 Do you want fries with that? CPE300 Crock-Pot Express Crock XL One Pot Cooker RHPC3000 11-in-1 Digital Multicooker RHAF15 5.7L Brooklyn Air Fryer RHRC20BLK Black Turbo Rice Cooker Tosties - the perfect lunch! Master familyamazingsnacks & meals FREESTANDING COOKERS WANT TO FAKE-MAC? Check out our facebook page for the recipe using the Sunbeam grill! At amazing prices! Also available in S/Steel 5
Fingerprintresistant finish!

Water Dispenser












SPEAK TO US ABOUT DELIVERY AND INSTALLATION SERVICES ON ANY WHITEWARE PRODUCT KEEP FOOD FRESHER FOR LONGER Choose a fridge that uses modern technology and innovative storage solutions. NEW! $ 829 $ 1059 $ 1099 $ 1249 $ 1499 $ 1799 $ 1899 $ 1949 $ 2199 $ 3399 Save $199 Save $600 HRF230BW 230L White Bottom Mount Fridge/Freezer • 1660H x 550W x 640D • Internal LED lighting • 144L volume in the refrigerator, 86L in the freezer HRF340BW2 342L White Bottom Mount Fridge/Freezer • 1702H x 595W x 642D • Frost free freezer • Multi directional air flow system ensures even cooling for optimum food storage • Crisper bin • Spill-proof safety glass shelves WBB3100WKX Westinghouse 308L White Bottom Freezer Refrigerator 1650H x 598W x 650D Full-width Dairy Bin with lid FlexStor™ door bin storage system Multi-flow Air Delivery Adjustable easy clean glass shelves • Separate temperature controls for fridge and freezer Reversible door HVF260WH3 258L White Vertical Freezer • 1670H x 595W x 685D • Touch LED temperature control • Plastic freezer drawers • Interior LED light • Eco function • Child lock MRCX328ERSTA 328L S/Steel Multi Drawer Fridge/Freezer 1698H x 600W x 660D 328 Litre Capacity Two-Way Flexi Shelf Humidity Drawer with Vitalight Technology Non-Plumbed Automatic Ice Maker HRF420BS 420L Satina Bottom Mount Fridge/Freezer • 1725H x 700W x 676D • Recessed handle design • Snap freeze groceries to preserve freshness with SuperFreeze™ RF402BRPX6 403L S/Steel ActiveSmart Bottom Mount Fridge/Freezer 1720H x 635W x 695D ActiveSmart™ technology Energy usage 465kWh/year Ultra flat door HRF575XC 575L Black Side-by-side Switchzone Fridge/Freezer • 1775H x 905W x 707D • Filtered cold water from the door • Multi-Zone air cooling system for consistent airflow NRBX421GUSA 377L S/Steel Bottom Mount Fridge/Freezer with Hygiene Water 1680H x 686W x 695D • Prime Fresh+ • Ag Clean suppresses odours • ECONAVI saves energy NRCW530JVSA 493L Silver Matt French Door Refrigerator with Water Dispenser 1730H x 750w x 750D Flexible temperature compartment with Prime Fresh Flexi • Fresh Safe Vegetable Case • nanoe™ X • Plumbed Filter & Auto Ice Maker Also available in S/Steel Also available in Black Also available in Satina REFRIGERATION
My Zone™ adjustable temperature drawer lets you change the conditions to chill drinks or preserve seafood and meat. TOP TIP Betta Frost free & quick response cooling with innovative super freeze technology. Switch Zone™ compartment lets you change the temperature between -18°C and +5°C, so you can use it as a fridge or freezer.
NEW! Water & Ice Dispenser Prime Freeze rapidly seals in freshness & nutrients BettaTOP TIP Humidity Zone™ bin creates the optimum environment for fruit and vegetables. 6














LOOKING FOR FRIENDLY, KNOWLEDGEABLE, AND EFFICIENT CUSTOMER SERVICE? Come and talk to us! CHOOSING A DISHWASHER Check the energy and water ratings to find the most environmentally friendly dishwasher to suit your needs. Look for wash programs that save water and energy! 13 Place White Dishwasher • 850H x 598W x 598D • AUTO wash to optimise your water & energy usage • Height adjustable upper basket • Lock function - to stop accidental opening $ 629 $ 1139 $ 829 $ 949 $ 999 $ 2379 $ 1599 $ 2049 $ 1479 $ 769 $ 1099 Save $100 Save $120 Also available in S/Steel HDW13V1W1 HDW15F2S1 15 Place Satina WiFi Freestanding Dishwasher 850 -895H x 597W x 599D • Six wash programs and four wash modifiers including Sanitise • Easily accommodates plate sizes up to 320mm • Wi-Fi connected for remote control using the SmartHQ™ app • 5 star water rating and 4 star energy rating 13 Place White Freestanding Dishwasher • 850H x 598W x 598D • Water efficiency star rating WELS 4.5 • Water consumption (litres) 11.8 • Energy Star Rating 3 • Energy consumption cold water (kWhr/yr) 295 Noise level dBA 49 5 wash programmes WSF6602WA 13 Place S/Steel Freestanding Dishwasher • 850H x 598W x 598D • 13 Place Settings • 5 Wash Programmes • Fast Wash Programme • Time Save Programme • Half Load Option • Adjustable Upper Basket WSF6602XA 14 Place S/Steel Freestanding Dishwasher • 850H x 600W x 600D • 14 Place setting • 8 Smart pre-set programmes • Economical use of energy and water • Overheat protection and anti-leaking sensor NP6F2MUQNZ DD60DCX9 14 Place S/Steel Double DishDrawer • 820-880H x 599W x 573D • 14 Place settings
Six wash programs, as
as additional Quick wash, Sanitise and Extra Dry options
Flexible racking
internal
your needs RC376W2 376L White Chest Freezer 847H x 1240W x 695D Two removable wire baskets for flexible storage WCM3000WE 300L Chest Freezer 847H x 1114W x 630D Quick chill function Removable, high insulation door seal Hovering Door SMS6HAI01A 14 Place S/Steel Freestanding Dishwasher Series 6 • 845H x 600W x 600D • 6 wash programs • HygienePlus • Favourite function: Save any combination of programs and options • ExtraDry • Home Connect SMS4HTI01A
Place S/Steel Freestanding Dishwasher Series 4 • 845H x 600W x 600D • 6 wash programs • HygienePlus • Extra Dry • EcoSilence Drive • 4 star Energy Rating • 4 Star Water Rating • Remote Start: Connect to WiFi via HomeConnect HCF201 201L^ Chest Freezer • 845H x 940W x 550D • Quick response cooling with innovative Super Freeze technology Wash one drawer whileyouload the other! DISHWASHERS Fast Freeze Function CHEST FREEZERS Lock in flavourfreshness,and nutrients! 7
•
well
•
allows you to customise
shelves to suit
14











$ 1049 $ 799 $ 1929 $ 1199 $ 979 $ 1099 $ 1329 Save $250 Save $50 NAF85AR1HNZ 8.5kg Top Load Washing Machine • 1069H x 600W x 672D • Active Foam System • StainMaster function NHE70JA1WAU 7kg Tumble Dryer • 850H x 600W x 565D • 4 drying programs • Wall Mountable/Stackable NAS106FR1WA 10kg/6kg Washer Dryer Combo 845H x 596W x 645D All-in-One Washer Dryer blueAg WA7060M2 Fisher & Paykel 7kg QuickSmart™ Top Load Washer • 1045-1075H x 600W x 600D • 4 Wash Cycles SmartDrive™ technology • 7kg capacity DE7060G2 Fisher & Paykel 7kg Sensor Vented Dryer • 830H x 600W x 575D • Reverse Tumbling • Six Fabric Care Dry Cycles • Drying rack WH8060J3 Fisher & Paykel 8kg SmartDrive Front Load Washing Machine • 850H x 600W x 590D • Nine wash cycles including Heavy, Delicate and Easy Iron DE8060P3 8kg Condenser Dryer 850H x 600W x 645D 13 dry cycles including Freshen, Heavy and Easy Iron Auto-sensing preventstechnologyunder or overdrying! LAUNDRY 6 wash programs AI Smart Wash! SmartDrive™ technology provides a quiet and gentle wash. BettaTOP TIP
GREAT

Simple touch controlpanel. 12washcycles






LAUNDRY ACCESSORIES











9 Make a Betta choice! WE'LL HELP YOU FIND THE RIGHT PRODUCT TO SUIT YOUR NEEDS NO LONGER A CHORE! These vacuums will take the 'work' out of house work! NEW! $ 109 $ 199 $ 349 $ 119 $ 289 $ 899 $ 649 $ 699 $ 699 $ 699 $ 899 $ 1 279 $ 1199 $ 2188 $ 1429 $ 679 $ 899 MCCL605KG43 Cyclone 2000W Bagless Canister Vacuum Cleaner • 2000W Powerful Input Power • 2.2L Big Dust Capacity Clean Air Exhaust via 6-layer Filtration System with HEPA 10502200 Blizzard CX1 Excellence Vacuum • Vortex technology • HEPA AirClean lifetime filter • Gore CleanStream fine dust filter • ComfortClean function • Multifunction rotary control 10502200 Boost CX1 Vacuum Cleaner • 890W maximum power • Vortex technology • Hygiene AirClean filter • TrackDrive wheels • Four-stage rotary power control • 6.5m cable length BCH87POW1 36V Max Athlet ProPower Rechargeable Vacuum 0.9 L Dust container volume Extra long runtime up to 80 min. 3 Variable speeds Rotation Clean for easy filter cleaning BGS41PETAU Series 6 ProAnimal Bagless Vacuum Red • 2.4 litre dust capacity • EasyClean System • HEPA hygienic filter HWT75AA1 Haier 7.5kg Top Load Washing Machine • 940H x 550W x 600D • 8 Wash Cycles HWT80AW1 Haier 8kg Top Loader Washing Machine • 970H x 580W x 590D • Super-fast 10-minute Quick cycle HDV60A1 Haier 6kg Sensor Vented Dryer • 830H x 600W x 585D • 7 programmes • Sensor drying • Reverse tumble HWF95AN1 9.5kg Front Load Washing Machine • 850H x 595W x 660D • 4.5-star water rating • 4-star energy rating HDC80E1 Haier 8kg Condenser
845H x 595W x 648D
Sensor drying
Anti-crease option
8kg Heat Pump Tumble Dryer Series 4 842H x 598W x 613D Highly efficient heat pump drying WAN24124AU 8kg Front Load Washing Machine Series 4 848H x 598W x 600D EcoSilence Drive
Dryer •
•
•
WTH83001AU
Haier
Washing Machine
HWF75AW3
7.5kg Front Loader
• 850H x 595W x 610D
2 in 1 Steamer Supreme Steaming Feature and Ironing Feature 656113
Universal Stacking Kit with Pull-out shelf 656112
Universal Stacking Kit with Pull-out draw
Cordless Iron
Fast 5 second re-charge
• With 12 wash cycles including Express 15 and Refresh – which uses steam RHC470
Meliconi
Meliconi
RHC580
•
PRICE! 9




















Q Card Terms & Conditions: *12 months interest free options are available on Q Card Flexi Payment Plans. Minimum purchase $299. Account fees may apply. A $55 Establishment Fee for new Q Cardholders and a $35 Advance Fee for existing Q Cardholders will apply. Q Card Standard Interest Rate applies to any outstanding balance at end of Payment Holiday. Payment Holiday period may vary depending on Q Cardholder’s payment cycle dates. Q Card lending criteria, fees, terms and conditions apply. This is valid for in-store purchases only. 55" & 65" ARRIVING SOON! Pre-order yours now! $ 2999 $ 569 $ 449 $ 249 $ 199 $ 59 $ 79 $ 1699 $ 2149 $ 57 Save $100 Save $50 When you purchase a Panasonic OLED, you’re getting industry leading picture quality, meticulously perfected through years of development and Hollywood collaboration. LX900 Series Premium 4K LED TV offers unbeatable performance for sport and gaming. Key step up features offering a brighter panel, deep contrast and 200hz Smooth Motion ensures you never miss a beat on this great display. Soundbars are the best way to get superior audio quality from your TV! They are available in a variety of configurations. For true deep black - OLED • Class-leading colour, contrast, clarity and Auto AI mode • Immersive sound quality for cinema Theater Surround Pro with Dolby Atmos® • Stunning speed, resolution and motion - Game Mode Extreme More viewing choice - Smart TV (my Home Screen 8.0) Create a Cinema Experience at home Give sport and gaming entertainment the performance they deserve 42" 55" 65" TAB5706 Soundbar 2.1 with built in subwoofer BLUETOOTHDUO Twin Pack of Bluetooth On Ear Headphones TYPHOON101 Typhoon 101 Bluetooth Speaker with Microphone SCHTB600GNK 2.1ch Soundbar SCHTB510GNK Chromecast Bluetooth Soundbar and Wireless Subwoofer IMT8000TR Sound Rover Mini 8 Portable PA Speaker TAS1505B Bluetooth Speaker Trouble hearing the sounddialogue... bars are your solution! Includesmicrophone andspeakerstand! SCHOOL HOLIDAYS ENTERTAINMENT! 10




















LOCAL S hop BETTA S hop PLEASE NOTE: Not all products are available in all stores, but can be ordered or purchased online www.bettaelectrical.co.nz while stocks last. YOU'LL FIND BETTA ELECTRICAL STORES NATIONWIDE OR CHECK OUT OUR WEBSITE www.bettaelectrical.co.nz TO FIND THE STORE NEAREST TO YOU CAMBRIDGE Steen & Morrow Betta Electrical 6 Commerce Street Phone: (07) 827 6591 GORE Connor & Fitzpatrick Betta Electrical 35 – 37 Medway Street Phone: (03) 208 6741 HAWERA T&H Betta Electrical 232 High Street Phone: (06) 278 4338 INGLEWOOD Matai Electrical Ltd 26 Matai Street, Inglewood Phone: (06) 756 7248 KAIKOHE Kaikohe Betta Electrical 133 Broadway Phone: (09) 401 0525 MOTUEKA Reliance Betta Electrical 174 High Street Phone: (03) 528 7120 OPUNAKE Sinclair Betta Electrical 31 Tasman Street Phone: (06) 761 8084 STRATFORD Sinclair Betta Electrical 212 Broadway, Stratford Phone: (06) 765 4499 REEFTON Greg Topp Betta Electrical 35 Broadway Phone: (03) 732 8118 WAIPUKURAU CHB Betta Electrical 46-48 Ruataniwha Street Phone: (06) 858 6077 WESTPORT AT Betta Electrical 148 Palmerston Street Phone: (03) 789 7719 AUTHORISED BETTA ELECTRICAL RESELLERS TURANGI Home & Heating Shop 20, Town Centre Phone: (07) 386 7008 WELLSFORD United Appliances Ltd 227 Rodney Street Phone: (09) 423 9060 BUILT-IN WI-FI BUILT-IN WI-FI NEW! $ 1599 $ 2799 $ 3499 $ 1899 $ 159 $ 249 $ 259 295H x 919W x 194D Cooling capacity - 3.5kW Heating capacity - 4.3kW ECONAVI and Inverter Technology Wide operating temperature range R32 refrigerant • NanoeX Installation Additional Panasonic 3.5kW/4.3kW AERO Series Air Conditioner • 295H x 919W x 194D • Cooling capacity - 4.2kW • Heating capacity - 5.1kW • ECONAVI and Inverter Technology • Wide operating temperature range • R32 refrigerant • NanoeX Installation Additional CSCUZ42XKR CSCUZ35XKR Panasonic 4.2kW/5.1kW AERO Series Air Conditioner Installation Additional MSZAP50VGKD • 299H x 798W x 219D • Capacity - Cooling: 5.0 kW • Capacity - Heating: 6.0 kW • Whisper Quiet • Night mode • Horizontal air flow • Energy efficient Mitsubishi Electric EcoCore AP50 High Wall Heat Pump Installation Additional MSZAP60VGKD 325H x 1100W x 257D Cooling capacity 6.0 kW Heating capacity 6.8 kW Whisper Quiet Energy efficient Mitsubishi Electric EcoCore AP60 High Wall Heat Pump RHPH1500LED Panel Heater 1500w with LED • 280H x 790W x 105D RHMH1500W Micathermic Heater 1500w 580H x 656W 267D RHMH2000W Micathermic Heater 2000w 580H x 780W x 267D
offer a comprehensive selection of air conditioners and heat pumps to keep your home or office cosy.
in store and talk to our well-trained teams, who can help you with choosing the model that is best for you, and help you with installation. HEAT OR COOL Comfort all year round, you wont want to leave home. FOR WINTERSnuggle up Warm up with Robinhood
We
Pop
Experience Clean Indoor Air Experience the benefits



With Panasonic’s latest range of Aero Series Air Conditioning, you can easily heat, cool & purify your home.

Enjoy the benefits of Panasonic’s exclusive nanoe™ X purification technology as it cleans using only the power of nature to give you fresh, clean air within your home and workspace.

nanoe™ X technology is not just a filter but a built-in purifier to clean the air you breathe - 24 hours a day, 7 days a week.

Inhibits Pesticides

Approved by Sensitive Choice New Zealand. nanoe™ X technology uses hydroxyl radicals to effectively inhibit airborne bacteria, mould, viruses, pollutants, as well as deodorises and tackles major allergins and pollen. It also works to fight adhered bacteria, such as doorknobs, light switches or any hard surface items where viruses may adhere itself.

nanoe™ X ensures the surfaces we touch and the air that we breathe is purified and clean all year round.

Tackles Allergens
Tackles Pollen
 What is nanoe™ X?
What is nanoe™ X?
Inhibits Mold Inhibits Bacteria & Viruses Deodorises nanoe™ X
of nanoe™ X
2.0kw Aero Series Air Conditioner FROM $1399

What is nanoe™ X?
What is nanoe™ X?